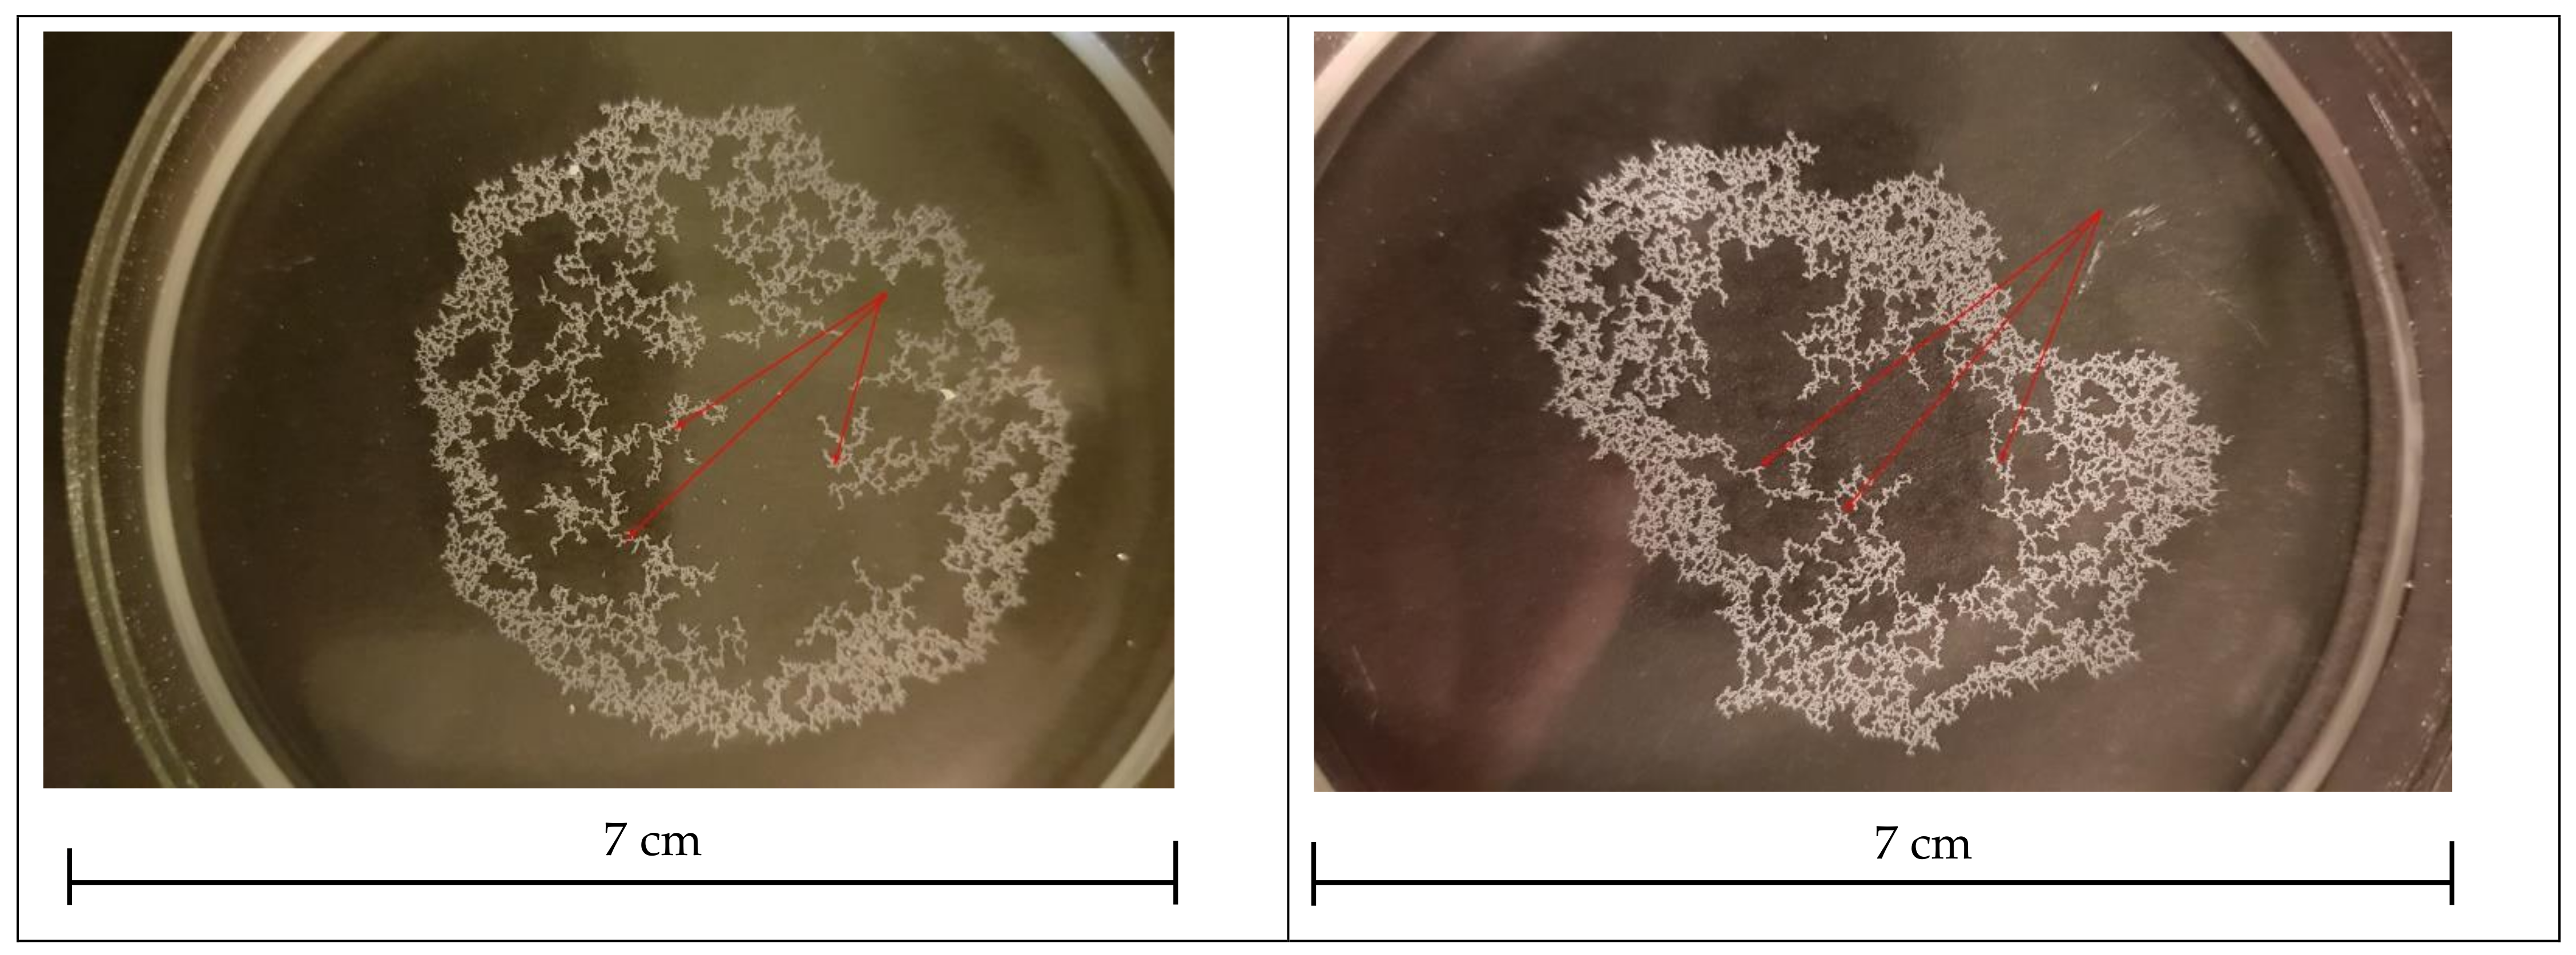
Sci 07 00048 g002

3.1. The Law of Motion
When analyzing the process of multi-hour clusterization of polyamide granules, we conclude that the action of van der Waals forces between the polyamide particles cannot cause clusterization in its initial stage. Smoluchowski’s coagulation theory [
3] uses the concept of a sphere of influence, the radius of which is taken as equal to that of colloidal micron-sized particles. It is assumed that when particles converge at this distance, they will conglomerate together under the action of dispersion forces. In our experiments, there is no motion of water that could lead to the convergence of particles. After sputtering at the beginning of the experiment, they are at a distance of hundreds of µm from each other; this is two orders of magnitude greater than the radius of the sphere of influence. This means that the electromagnetic forces that lead to the convergence should be described otherwise.
In the middle and late stages of observation, linear fragments can be seen in the structure of the clusters that are characteristic of the consolidation of dipoles [
21,
22,
23], the formation of metal “leaves” during electrolysis of zinc sulfate [
24], and the growth of dendrites from impurity barium particles in liquid helium in an electric field [
25]. This suggests that the clusterization of polyamide granules occurs under the action of electrostatic forces.
It is known that a large static charge can accumulate on the surface of polymers, including polyamide [
26]. There is a vast amount of literature on the study of the triboelectric effect, which is the emergence of electric charges on the dielectric surface because of friction. After applying various methods of electrization, some polymers can gain charges of opposite signs [
27,
28], which remain on the surface for a long time.
The triboelectric effect was investigated in granules of various polymers, including polyamide-12 [
28]. The granules of the substances under study with a diameter of 3 mm, which were subjected to neutralization, were placed into a container made of the same material. There, they were mixed with an air jet and then poured into a separator. There, under the action of an electric field, they fell into different sections depending on the sign and value of an electric charge gained as a result of friction against each other and the container walls. Figures in the Ref [
28] illustrate the dependence of an average density of the surface charge on polyamide-12 granules on the duration of mixing in the container. It shows that the granules gained charges of different signs, from
to
C/m
2, during electrization.
We assume that polyamide-12 granules may gain charges during manufacturing, packaging, transportation, and procedures when conducting experiments due to mutual friction. Moreover, electrization can be more efficient than in the experiments [
28] since, in our case, the granules are smaller by two orders of magnitude.
Based on the method used in [
21] for investigating an interaction between magnetic macrodipoles with opposite dipole moments, the law of motion of granules and clusters during their convergence can be established.
Particles are affected by electrostatic forces of attraction related to the presence of an electric charge on the granule surface. Moreover, neutral granules are attracted to charged ones due to polarization. We denote the force of electrostatic interaction by . In addition, a moving particle is affected by the resistance force of the medium , which is proportional to its velocity.
It is assumed that a cluster and a granule or two clusters do not have velocity components that are perpendicular to the conventional line connecting these two particles, i.e., that they move strictly toward each other.
We assume that the particle motion is completely dissipative, i.e., that the sum of the forces of electrostatic attraction
and medium resistance
acting upon each particle equals zero. Then, in the most general case, the law of motion for each particle will have the form
where
x is the distance between the particles, and
is the time. In an ideal situation, if convergence occurs due to the presence of two opposite charges of particles,
. If one particle carries a charge of one sign, and another has a dipole moment,
. Two dipoles interact according to law (1), where
; in case of the interaction between charged and neutral particles,
. Approximation (1) is valid for point charges and dipoles.
As the origin of coordinates, we take the point where the particles will merge as a result of motion toward each other.
For the first and second particles, it follows from the equations of dissipative motion that
By summing up two Equation (3) for
, i.e., for the distance between the particles, we obtain the equation
3.2. Results of the Experiment
The dependence t(x) can be plotted from the video. The fitting of the obtained experimental dependence by a curve of the form (4) permits gives the values of b and c.
The dots in
Figure 5 show the experimental values of
x at the moments of time
t, which were obtained when processing several videos. The dependencies are well fitted by curves of the form (4), for which
c is 4 (a) and 5 (b). The standard deviation for
c, which was calculated by the fitting procedure, did not exceed 5% for all 42 curves of this kind obtained from video processing.
Figure 6 provides information about the times of observation
t0 in our series of experiments and the obtained values of the power exponent
c (4). The observations in the sodium chloride solution and distilled water are shown with solid and open circles, respectively.
The values of vary from 3 to 5.3; at t0 > 30 s, these values are near integers 4 and 5 for most observations. The ranges of values of for distilled and salt water turned out to be the same.
Figure 7 shows what values of
c were obtained at different
x0, i.e., the distances between converging particles at the beginning of the video recording. Like
c(
t0), the figure demonstrates the proximity of the power exponent to integers for a large number of observations. This fact is reflected in the histogram in
Figure 8, in which there are two peaks near numbers 4 and 5 despite a small number of observations in terms of statistics.
The velocity v of convergence of the particles just before aggregation was calculated from the videos when the distance between them was about several µm. It turned out that the values of v did not exceed 1 mm/s. This means that the interaction of clusters should not distort the pattern of liquid flows if there are not too many decorating particles and characteristic flow velocities are significantly higher than v. The obtained maximum value of the velocity allows estimating the Reynolds number Re = vρr/η, where v = 0.1 cm/s, ρ = 1 g/cm3, r = 0.002 ÷ 0.02 cm, η = 0.01 g cm2/s, Re ≈ 0.02 ÷ 0.2, which rules out turbulence during the motion of clusters and granules.
3.3. Discussion
Assuming that there are charges of opposite signs on the granule surface, it is possible to interpret the results of processing the videos as follows. It is known [
29] that if there is any generally neutral set of charges, far enough from this set, the potential created by it turns out to be dipole:
Here, is the value of an individual charge, is the radius vector that determines the position of qi relative to the origin of coordinates located inside the set of charges, and is the projection of on the radius vector .
If the total charge of the cluster is
, its potential has the form
When, during the processing of the videos, we obtain the values of (4) close to integers 3, 4, or 5, this can be interpreted as follows. In the first case, the dipole moments of the clusters are zero, and they interact as particles with opposite charges . In the second case, the dipole moment of one of the clusters is nonzero, and its total charge is zero; for another cluster, the opposite is true. In the third case, the total charges of both clusters are zero, and the dipole moments are nonzero.
However, in our observations of the convergence of granules and clusters, the distances between them are comparable with the sizes of the interacting objects. Therefore, strictly speaking, they cannot be regarded as either point charges or point dipoles. Since the observed clusters are large, the granules they consist of carry charges of opposite signs, the distribution of which has a complex form. Nevertheless, the electrostatic interaction of granules and clusters as point dipoles and charges can be examined based on the following qualitative considerations.
Figure 9 shows two converged clusters. They consist of some number of granules, each of which can be neutral or charged. The structure of charges of the cluster should exhibit periodicity related to its formation from opposite charges. The action of positive and negative charges will be mostly compensated at some distance from the cluster; then, the electric field is generated by one or two opposite charges, which have a value greater than the average one and are located closest to the cluster with which the first cluster interacts. According to this scheme, the clusters in
Figure 9 interact as two dipoles.
Following the proposed model, simple estimations of the density of a charge on the granules can be made. By comparing them with the values of
C/m
2 ([
27,
28]), it is possible to evaluate the degree of reliability of our conclusion about the nature of interaction between polyamide granules in water. We use the most general laws of electrostatics, considering water as a medium with the permittivity
.
The estimations were made for the processes of convergence to which the values of
close to the integers 4 and 5 correspond. Let us assume that the action of charges of opposite signs that form the cluster is compensated in a place where another cluster or granule with which it interacts is located. Only one point charge or two point charges of opposite signs located near the cluster boundary determine electrostatic attraction. Its force is
for the point charge
and the point dipole
or two dipoles
and
, respectively. Formula (7) is valid when the dipole moments lie in the plane of the water surface and are co-directional in case of the interaction between two dipoles.
The resistance force
is estimated from Stokes’ formula:
where
is the dynamic viscosity coefficient,
is the radius of a moving spherical particle, and
is its velocity. In this approximation, a large cluster can be regarded as a disk. Then, in formula (8),
, where
is the radius of the disk. Strictly speaking, formula (8) cannot be used to describe the motion of particles near the liquid surface. However, our estimations do not claim to have good accuracy.
Taking into account (7) and (8), the law of motion of converging particles (4) takes the form
for the charge–dipole interaction and
for the dipole–dipole interaction, respectively; indexes 1 and 2 correspond to the first and second particles.
The approximation of the experimental data by curves of the form (4) gives the value of the coefficient
(4). The charge
and dipole moments
and
can be expressed in terms of the granule radius
, the dipole length
, and the charge density
:
From (9) and (10), we obtain an expression for the density of the surface charge on the granule:
The estimation of was made by taking into account the sizes of the clusters and the granules forming them. The radius of the granules was in a range of 10–30 µm, and the length of the dipole is of 100 µm order. The sizes of the granules and clusters, which were observed in the experiments and determine , can range from 30 to 200 µm.
The values of
were calculated according to formulas (11) for 15 curves of the form (9) and (10) at
and
80, which are the permittivity of air and water. The results are demonstrated in
Figure 10. For all experiments, our estimations give
C/m
2 at
, which agrees with the results from [
28]. Calculations at
80 give overestimated values of
that correspond to the immersion of granules and clusters into water to a significant depth. Actually, they are separated from the interface by a very thin layer of water.
3.4. Effect of Screening
In water, and especially in a salt solution, there are positively and negatively charged ions. Owing to them, an electric field generated by the charges on the granules should be screened well. The length of screening in water can be estimated according to the Debye– Hückel theory for diluted electrolytes:
where
is the ion charge,
is the Faraday constant,
is the absolute temperature,
is the gas constant,
= 80 is the permittivity of water, and
mol/L is the ion concentration. A 4% NaCl solution is not a diluted electrolyte. In this case, the length of screening can be affected by many factors that we cannot take into consideration. The inefficiency of screening in our case may have two reasons. The characteristic size of the granules is 20 µm, and neighboring granules in the cluster may have opposite charges. If a neutral granule is adjacent to a charged one, a charge of the opposite sign is induced on the part of its surface that touches the charged granule. Therefore, ion clouds surrounding the granules have opposite charge signs and a significant overlap area. This is the first reason. The second one is that “submerged” granules and clusters are located at a micron distance from the water surface, which is characteristic of van der Waals forces. Hence, the electric field is not screened completely from the water–air interface. This is confirmed by a simple experiment. A voltage of 1 kV was applied to a test probe located 2–3 mm above the surface of water with polyamide clusters. A considerable number of clusters polarized by an external field and moving toward an increase in the electric field merged into a large cluster 5 min after applying the voltage (
Figure 11). Therefore, an external electric field passes through a thin layer of water, and, hence, charged granules can interact in the absence of an external field due to the incomplete screening of the charge from the water–air interface.
It is possible to compare the electric field at the distance from which the clusters floated to the test probe to that generated by an individual charged granule at a distance characteristic of our observations of the cluster convergence. Under a voltage of 1 kV, the test probe with a radius of the hemispherical tip of 0.25 mm generates an electric field of ~2500 V/m at a distance of 1 cm. A spherical granule with a surface charge density of 10–6 C/m2 and a radius of 20 µm generates an electric field of ~400 V/m at a distance of 100 µm. The estimations were made for the vacuum. In our experiments, the external field and the field of a charged granule were comparable in value.